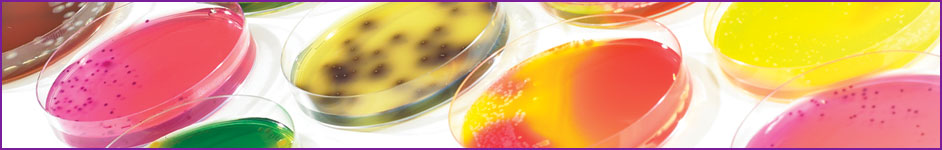

Microbiological effects of food processing
A new member–funded project will fill an important gap in food industry literature – a compilation of the effects of food and drink processing on microorganisms.
Whilst there is a considerable volume of data available, there is no single, definitive, fully–referenced source of information on the effects of processes on problem microorganisms (e.g. D values, z values, organism survival, deviations of death kinetics, protective effects of specific ingredients and foods) – despite its potential usefulness to industry. This project will compile and publish a definitive reference guide to the effect of antimicrobial processes on different microbial groups.
Additional control measures
The range of food and drink types and manufacturing processes used will consider the microbiological implications that result from changes from one moisture content to another, or from one temperature regime or heating system to another, and the subsequent applicability of the data. Such evaluations will include exceptional examples of when organisms are just injured and not destroyed and explain how these foods must have additional control measures to preserve the product throughout its shelf life.
Follow the progress of the project on the web page.
Contact: Joy Gaze
+44(0)1386 842064
joy.gaze@campdenbri.co.uk